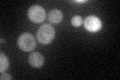
YJL042W

View description
Microtubule-associated protein involved in assembly and stabilization of microtubules; overproduction results in cell cycle arrest at G2 phase; similar to Drosophila protein MAP and to mammalian MAP4 proteins
Localization:
Intensity:
Fold change:
Significance:
-
C’ GFP library in SD
cytosol36.78 -
N' NOP1pr-GFP in SD

cytosol86.755 -
N' TEF2pr-mCherry in SD

below threshold5.46587 -
N' NATIVEpr-GFP in SD

cytosol21.1386 -
N' TEF2pr-VC and Cyto-VN in SD

#N/A0 -
C’ GFP library in SD+DTT

cytosol46.51.26No -
C’ GFP library in SD+H2O2

cytosol42.071.14No -
C’ GFP library in Starvation Media

cytosol41.21.12No -
C’ GFP library on the background of Pup2-DaMP

cytosol -
C’ GFP library on the background of CCT mutant

cytosol44.6241.21309No
